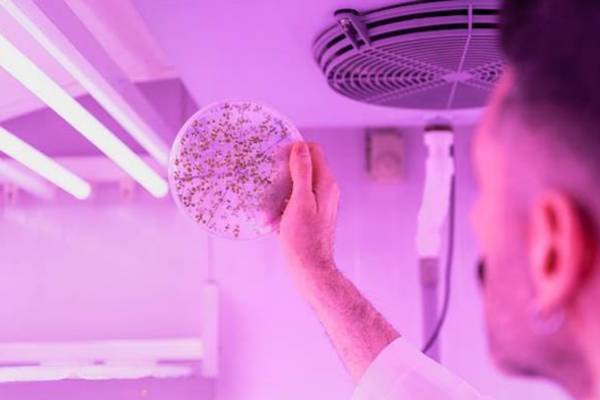

Un estudio publicado en Science ha identificado el mecanismo por el que una pequeña molécula regula la formación de los tejidos vasculares en las plantas, con posibles implicaciones a largo plazo para la agricultura y la biotecnología vegetal. El trabajo ha contado con la participación del Instituto de Biología Molecular y Celular de Plantas (IBMCP), centro mixto del CSIC y la Universitat Politècnica de València.
La molécula implicada, la termoespermina, actúa como un interruptor biológico capaz de controlar la producción de proteínas esenciales para el desarrollo del xilema, el tejido encargado de transportar agua y dar soporte estructural a las plantas. El estudio demuestra que esta regulación solo es posible cuando los ribosomas —las estructuras celulares responsables de fabricar proteínas— presentan una modificación química específica, catalizada por la enzima OVAC.
El ribosoma como sensor metabólico
La aportación conceptual más relevante del trabajo reside en una nueva comprensión del papel del ribosoma: más que una simple maquinaria de síntesis de proteínas, puede actuar como un sensor que integra señales metabólicas y regula selectivamente la traducción de genes concretos. Esta especialización funcional dependiente de la composición química del ribosoma constituye un campo poco explorado en biología molecular vegetal.
En la parte experimental, el equipo del IBMCP demostró que la termoespermina solo puede modular la producción de dos factores clave del desarrollo vascular —SACL y LHW— cuando los ribosomas están previamente metilados por OVAC. El equilibrio entre ambas proteínas determina el destino de las células vasculares: si se diferencian en vasos conductores de agua o en células de almacenamiento. Para probarlo, utilizaron un sistema de análisis de eficiencia traduccional en protoplastos de Arabidopsis, la planta modelo de referencia en este tipo de investigaciones.
Las aplicaciones prácticas son aún prospectivas, pero los investigadores señalan que comprender este mecanismo podría contribuir en el futuro a ajustar el desarrollo del xilema en cultivos, con efectos potenciales sobre la formación de raíces y órganos de almacenamiento, la eficiencia en el transporte de agua o la producción de biomasa y madera.
El consorcio internacional que ha llevado a cabo la investigación está liderado por la Universidad de Cambridge y la Universidad de Helsinki, con la participación de centros de Europa, Asia y Estados Unidos.





Política de comentarios:
Tenemos tolerancia cero con el spam y con los comportamientos inapropiados. Agrodigital se reserva el derecho de eliminar sin previo aviso aquellos comentarios que no cumplan las normas que rigen esta sección.